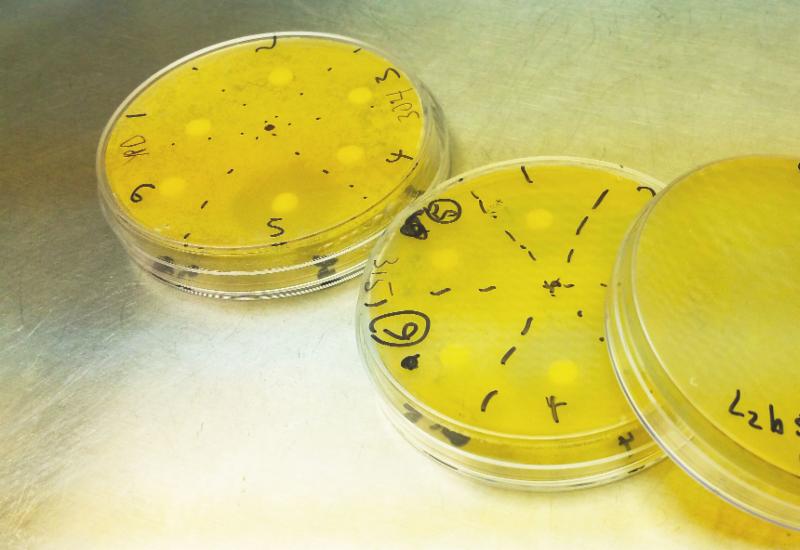

News
Multiplex Apoptosis and Necrosis
Multiplex Apoptosis and Necrosis
Necrosis is characterized as a passive, accidental cell death resulting from environmental perturbations with uncontrolled release of inflammatory cellular contents. Loss of plasma membrane integrity represents a straightforward approach to demonstrate late stage apoptosis and necrosis.
Cell Meter™ Apoptotic and Necrotic Detection Kits are a set of tools for monitoring cell viability. The kits are optimized to simultaneously detect cell apoptosis, necrosis and healthy cells with a flow cytometer or fluorescence microscope. The phosphatidylserine (PS) sensor used in Kit 22843 has deep red fluorescence (Ex/Em = 630/660 nm) upon binding to membrane PS. Membrane-impermeable Nuclear Green™ DCS1 (Ex/Em = 490/525 nm) is used to label the nucleus while CytoCalcein™ Violet 450 (Ex/Em = 405/450 nm) is provided for labeling live cell cytoplasm.
Key Features of Cell Meter™ Apoptotic and Necrotic Detection Kits (pg 15-16 of this catalog):
• Multiplexing capability, triple colors for the simultaneous detection of multiple cellular events.
• Robust, a mix and read format.
• Convenient, compatible with common filter sets.
|
|
|
The fluorescence images of Jurkat cells showing cells that are alive (blue, stained by CytoCalcein™ Violet 450, Cat# 22012), apoptotic (green, stained by Apopxin™ Green), and necrotic (red, indicated by 7-AAD staining, Cat# 17501). The fluorescence images of the cells were taken with Olympus fluorescence microscope in the Violet, FITC and TRITC channel respectively. Individual images taken in each channel from the same cell population were merged as shown above. B. Non-induced control cells. C: Triple staining of staurosporine-induced cells (1 μM staurosporine treatment for 3 hours.)
|
|
|
|
The detection of apoptosis and necrosis with Kit 22843. Binding activity of Apopxin™ Deep Red to phosphatidylserine in Jurkat cells. The fluorescence imaging demenstrated that live cells (blue) were stained by CytoCalcein™ Violet 450 (Cat# 22012), apoptotic cells (red) were stained by Apopxin™ Deep Red, and necrotic cells (green) were stained by Nuclear Green™ DCS1 (Cat# 17550). Apoptosis was induced by 1 μM staurosporine for 3 hours. The fluorescence images of the cells were taken with Olympus fluorescence microscope using the Violet, Cy5® and FITC channel respectively. Individual images taken in each channel from the same cell population were merged as shown above. A: Non-induced control cells; B: Triple staining of staurosporine-induced cells.
|
Product Ordering Information:
Cat# 22840 Cell Meter™ Apoptotic and Necrotic Detection Kit *Triple Fluorescence Colors*
Cat# 22843 Cell Meter™ Apoptotic and Necrotic Detection Kit *Triple Fluorescence Colors*
Introducing Human Gingival Cells From Lifeline!

Introducing NEW Gingival Cells From Lifeline

Lifeline's Human Oral Keratinocytes (from Gingiva) and Human Gingival Fibroblast are cryopreserved as secondary cells to ensure the highest viability and plating efficiency.
The Human Oral Keratinocytes ( from Gingiva) are quality tested in DermaLife K Medium to ensure proper growth and morphology over a period of at least 15 population doublings.
The Human Gingival Fibroblast cells are quality tested in FibroLife Medium to ensure proper growth and morphology over a period of at least 15 population doublings.
Each of these cell systems provide models for studying Gingival wound healing, basic oral biology and toxicology.

Related Gingival Products
FC-0094 , HOKg, Normal Human Oral Keratinocytes from Gingiva
FC-0095 , HGF, Normal Human Gingival Fibroblasts
LL-0007 , DermaLife K Medium Complete Kit
LL-0001 , FibroLife Serum-Free Medium Complete Kit
LL-0011, FibroLife S2 Medium Complete Kit
LL-0013 , TrypKit Subculturing Reagents
LM-0015, FrostaLife Cryopreservation Solution
Bovine Serum Albumin (BSA) from Gold Biotechnology
Bovine Serum Albumin (BSA) comes in many forms, which is why people frequently post questions online, asking what BSA should be used in their experiment. Forum responses have been good about directly addressing the procedure in question, but it's really hard to find a consolidated resource that helps researchers evaluate each type of BSA and their appropriate uses. Since the Internet is lacking a central guide, I set out to investigate what goes into choosing between BSA types and provide these answers in this article.
First, we should address what types of BSA exist in the market. GoldBio offers two types: protease free and fatty acid free (I’ll explain why fatty acid free is a good choice for many experiments later on in this article). But then you have other types of BSA, such as standard BSA, low endotoxin, immunoglobulin free and blocking agent BSA. Obviously each type offers certain features that may help or hurt your project. So which one is best for your experiment?
To figure this out, we should look at common processes that use BSA:
- Cell Culture
- ELISA
- Enzyme System Diluent
- Immunology
- Protein Stabilization
- Carrier Protein
One Chart to Rule Them All
Which one of these six common methods are you using? That’s going to be what helps you decide which BSA is right for your experiment. Certain types of BSA will cover a multitude of techniques; for that reason, it is better to address which BSA types are appropriate for each process in a simple chart rather than long paragraphs where overlaps aren't as evident.
BSA Selection Guide Chart - What BSA (Bovine Serum Albumin) Should I Use – Your BSA Selection Guide
Beyond the Chart:
The chart certainly reduces having to do heavy research into finding the best option. It also makes it clear that there are certain BSA types that reach further than others. For example, it's obvious that fatty acid free BSA and protease free BSA works well in a wide variety of techniques, making each a more ideal product, while a blocking BSA is best used only as a blocking agent in ELISA.
But beyond these criteria, there are other very important factors to consider. Number one is usually price. Being sure it fits the budget is make-or-break for almost every researcher. The next go-to for a researcher is purity. But let’s say you found the right BSA type, it fits your budget and it has excellent purity, what else should you consider? When evaluating BSA, the location it’s manufactured in and if it’s certified as bovine spongiform encephalopathy compliant is also vital for obvious reasons.
Why Choose Fatty Acid Free BSA?
The factors mentioned in this article are exactly what GoldBio considered when first offering protease free BSA, and then more recently our fatty acid free BSA, which is also protease free. We were determined to provide researchers with a product that satisfies most criteria for BSA selection. First, they’re both extremely affordable and have high purity. Beyond that, however, both products are manufactured in the USA and are BSE/TSE compliant. And while GoldBio’s protease free BSA is appropriate for a variety of common techniques, we recently introduced fatty acid free BSA because it is useful in an even broader range of experiments, not just the ones listed on the chart. Besides satisfying some check boxes, fatty acid free BSA eliminates certain variables from the experiment. In fact, there are times when the nature of the experiment necessitates the use of fatty acid free BSA over others. For instance, if you're working with a fatty acid sensitive cell culture system such as CHO, Vero and MDCK cells, fatty acid free BSA is more suitable for those situations.
Of course both products have their limits. They won't be ideal for processes such as PCR or bloodbanking, but in general, both BSA types, and more particularly the fatty acid free BSA will allow you to stretch the product over a wider variety of techniques without costing much more. Economically, it's a better choice. And if you still question whether this product or other BSA types are right for you, it’s best to do additional research to be certain.
If you found this guide useful, you might want to share it with others and check out some of our other articles, which are both helpful and entertaining.
Rac1 Regulation ASCB 2015 Abstract

Temporal regulation of phosphotyrosine-modified Rac1 in response to epidermal growth factor stimulation
Abstract
The aim of this study was to develop an assay sensitive enough to detect endogenous pY‐modified Rac1 uponstimulation by EGF. The IP assay was used in conjunction with a Rac1 activation assay to follow temporal changesin endogenous Rac1 activation and tyrosyl phosphorylation in response to EGF stimulation of HeLa and A431 cells. Rac1 activation, monitored by PAK‐binding, followed a predicted time course in which...
Click here to read more.
Link to citation:
Law A., Hong S., Horita H. and Middleton K. 2015. Temporal regulation of phosphotyrosine-modified Rac1 in response to epidermal growth factor stimulation. Mol. Biol. Cell. ASCB Abstract Dec. B1230 / P2126.
Products used in this citation:
- Rac1 Pulldown Activation Assay Kit (Cat. # BK035)
- Anti-Phosphotyrosine HRP conjugated (Cat. # APY03-HRP)
- Anti-Phosphotyrosine Affinity Beads (Cat.# APY03-beads)
Creative Bioarray - Propelling Your Research

Creative Bioarray is an innovative biotechnology company whose mission is to develop unique technologies that provide researchers with the tools to investigate life science through the development of novel cell based personalized medicine therapeutics that prevent, treat or cure disease. We provide a wide range of high quality human cancer cell lines, human primary cells and Animal cell lines. Furthermore, Creative Bioarray manufactures products out of the cell lines i.e. genomic DNA, RNA, whole cell lysates and snap frozen cell pellets.
Human Tumor Cells
|
Cell Category
|
|||
| Breast Tumor Cells | Skin Tumor Cells | Head-Neck Tumor Cells | Adrenal Gland Tumor Cells |
| Hepatoma Tumor Cells | Colon Tumor Cells | Soft Tissue Tumor Cells | Urinary Bladder Tumor Cells |
| Liver Tumor Cells | Leukemia Tumor Cells | Lung Tumor Cells | Bone Tumor Cells |
| Kidney Tumor Cells | Colorectal Tumor Cells | Prostate Tumor Cells | Gastric Tumor Cells |
| Bain Tumor Cells | Pancreas Tumor Cells | Myeloma Tumor Cells | Oral Tumor Cells |
Human Primary Cells
|
Cell Category
|
||||
| Bone Marrow Cells | Lymphatic Cells | Hepatic Cells | Cardiac Cells | Renal Cells |
| Skin Cells | Dermal Cells | Epidermal Cells | Adipose Cells | Endocrine Cells |
Animal Primary Cells
|
Cell Category
|
||||
| Monkey Cells | Bovine Cells | Canine Cells | Hamster Cells | Chicken Cells |
| Mouse Cells | Opossum Cells | Rat Cells | Pig Cells | Potoroo Cells |
BioPointe Scientific Extended Tips

Our Extended tip allows you to get to the bottom of a 1.5 ml centrifuge tube without the risk of your pipettor inadvertently coming into contact with the inside of your tube. This is a simple but effective way to prevent carry-over contamination. Reference Lines: 2μl, 10μl

Contact us at 6775 7318 or email custcare@axilscientific.com to enquire.
New Featured Zebrafish-validated Antibodies from GeneTex
|
New Featured Zebrafish-validated Antibodies from GeneTex |
|||||||||||||||||||||||||||||||||
|
|
|||||||||||||||||||||||||||||||||
| Zebrafish has emerged as an outstanding model organism for biomedical research. GeneTex is proud to offer a comprehensive and rigorously validated collection of antibody reagents for use with zebrafish samples. The images above highlight our latest products. Please see below for part of our cited zebrafish antibodies or click here to visit our website for more information. | |||||||||||||||||||||||||||||||||
|
Respiratory Cells in Research - A New Blog From Lifeline
|
Breathing is Something We Take Very much for GrantedOxygenated air enters through the mouth or nose and passes into the trachea. The trachea branches into two bronchi, which lead to each lung. The bronchi divide into progressively smaller branches, called bronchioles. At the end of bronchioles are alveoli, sacs that mediate the exchange of oxygen and carbon dioxide. A layer of epithelial cells lines the respiratory tract. This epithelium provides a barrier against the external environment and protects against infection from airborne pathogens. Defective barrier function or viral infection can lead to respiratory tract disease. Visit http://blog.lifelinecelltech.com to find out more.
|
GBT - All About Antibiotics
![]() |
|||||||||
| Get Important Content Below | |||||||||
| Antibiotic Disc Diffusion Assay | Antibiotic Testing Procedure | ACES | CAPS | ||||||
|
At GoldBio, we like to be sure you're truly equipped when it comes to research. We not only have the products, but we also provide loads of information to keep your project on the right track. Take a look at the content that supports our high-quality research antibiotics: |
|||||||||
|
|||||||||
| Check out some of these antibodies below! | |||||||||
| Ampicillin | 25 g | ||||||||
| Carbenicillin | 25 g | ||||||||
| Chloramphenicol | 25 g | ||||||||
| Hygromycin | 2x1 g | ||||||||
| Kanamycin | 25 g | ||||||||
| Vancomycin | 5 g | ||||||||
|
Featured Buffers: ACES & CAPS |
|||||||||
|
|||||||||